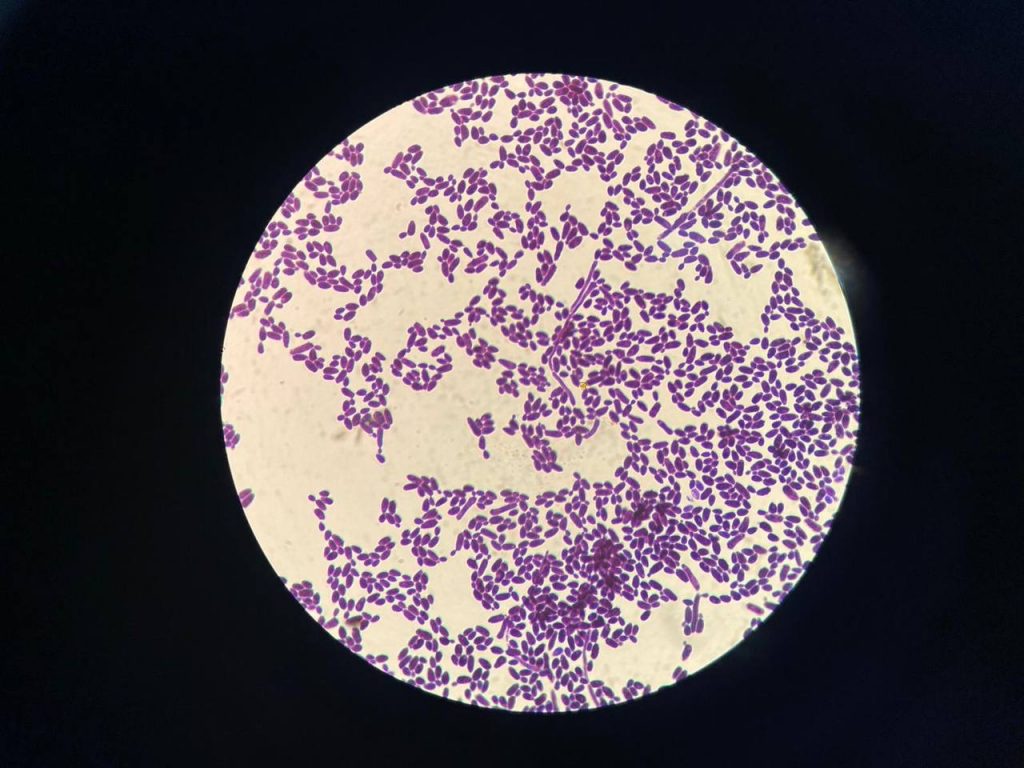

Ēnu diena 2023
Šodien mūsu skolas jaunieši piedalījās ikgadējā ,,Junior Achievment Latvia” rīkotajā Ēnu dienā. Mūsu skolas skolēni viesojās visdažādākajās darba vietās, iepazīstot sev interesējošas profesijas.
👩💼👨💼Skolēni apmeklēja Saeimu, ēnojot deputātus, iepazīstot frakciju darbību, jauniešiem bija iespēja klātienē vērot ārkārtas sēdi, kurā pieņemts vēsturisks likums par obligāto militāro dienestu. Ksenija Sanduļaka ēnoja partijas “Latvija Pirmajā vietā” deputāti Ramonu Petraviču, taču Kristiāns Priedītis un Elīza Ipoļitova ēnoja partijas “Jaunā Vienotība” deputātu Hosamu Abu Meri.
👨✈️✈️Klāvs Balsers ēnoja AirBaltic pilotu, iepazīstot nianses pilota darbā, kur bija iespēja piedalīties simulācijās.
👮♀️🐶Anna Frolova apmeklēja Valsts policijas koledžu, kur iepazina kinoloģijas pamatus, dzīvnieku apmācību, tāpat Annai bija iespēja apmeklēt SkillsLatvia izstādi.
🧑🔬🧪Deivids Uļskis ēnoja Rīgas Austrumu klīniskās universitātes slimnīcas laboratorijas darbinieci, iepazīstot profesijas nianses, iespēja iepazīt darbu arī praktiski.
🧑🍳🎂Simona Valtere un Aleksandra Šakale devās ēnot uz Siguldu. Meitenes ēnoja konditoreju “Kūkas gardas”, kur radīja savu torti, sākot ar receptes plānošanu, līdz dekorēšanai un nosaukumam.
🧑⚖️🔍Nensija Zeidlere un Evelīna Grinkeviča iepazina vietējo Saldus rajona tiesu, kur ēnoja tiesnesi, izzinot svarīgo šajā atbildīgajā profesijā.
Pieredzes bagāta un vērtīga diena karjerai un izaugsmei!